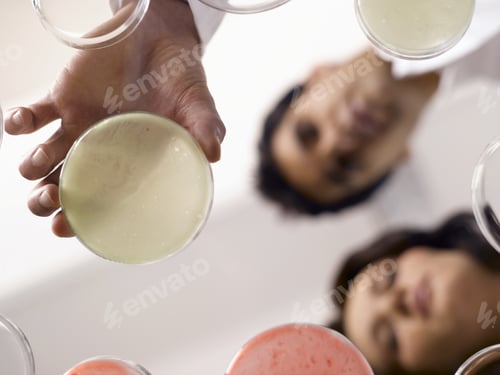
Visualização: Visão de baixo ângulo de cientistas observando placas de Petri

Fotos de Bebida Sem Direitos Autorais
Procure as fotos de stock do bebida em nossa biblioteca. Se você não conseguir encontrar sua foto à primeira vista, tente usar filtros!
Não deixe de dar uma olhada em nossa biblioteca de videos de estoque de bebida
Relacionado:Drink
drink
Relacionado:Refrigerante
refrigerante
Relacionado:Bebidas
bebidas
Relacionado:Bebida Alcoolica
bebida alcoolica
Relacionado:Bebida Na Praia
bebida na praia
Relacionado:Bebado
bebado
Relacionado:Pessoa Na Praia
pessoa na praia
Relacionado:Pessoas Na Praia
pessoas na praia
Relacionado:Bem-estar
bem-estar
Relacionado:Corrida Na Praia
corrida na praia
Relacionado:Bebé
bebé
Relacionado:Bebe
bebe
Relacionado:Areia De Praia
areia de praia
Relacionado:Pessoa Bebendo
pessoa bebendo
Relacionado:Por Do Sol Praia
por do sol praia
Relacionado:Drink
drink
Relacionado:Refrigerante
refrigerante
Relacionado:Bebidas
bebidas
Relacionado:Bebida Alcoolica
bebida alcoolica
Relacionado:Bebida Na Praia
bebida na praia
Relacionado:Bebado
bebado
Relacionado:Pessoa Na Praia
pessoa na praia
Relacionado:Pessoas Na Praia
pessoas na praia
Relacionado:Bem-estar
bem-estar
Relacionado:Corrida Na Praia
corrida na praia
Relacionado:Bebé
bebé
Relacionado:Bebe
bebe
Relacionado:Areia De Praia
areia de praia
Relacionado:Pessoa Bebendo
pessoa bebendo
Relacionado:Por Do Sol Praia
por do sol praia
Quão satisfeito você está com sua experiência Fotos hoje?

Bebida
Beer